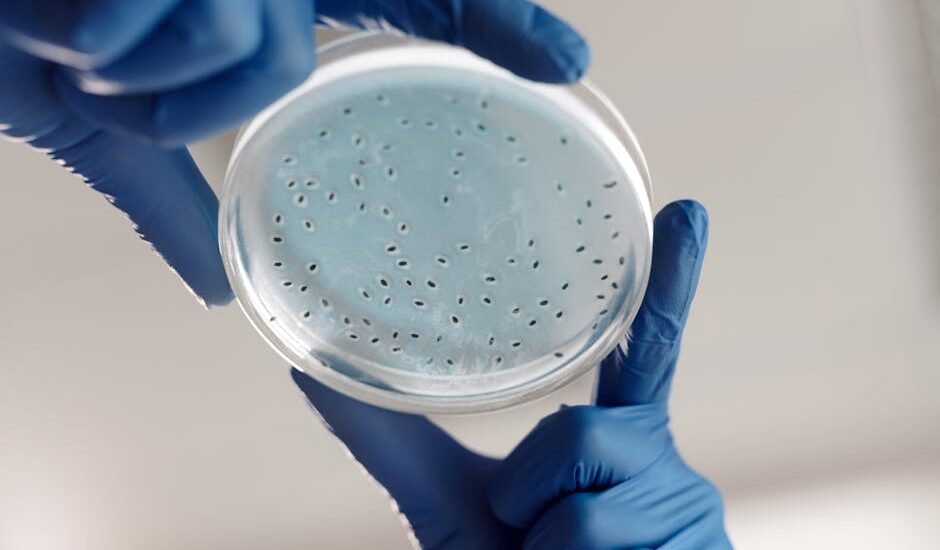
Close-up of gloved hands holding a petri dish with bacterial cultures in a lab.

The field of biotechnology has witnessed significant advancements in recent years, with a major focus on understanding the complexities of various diseases, including type 2 diabetes, neurodevelopmental disorders, and metabolic diseases. Studies have shown that multiancestry, tissue-specific genetics play a crucial role in informing the etiology of type 2 diabetes, while the gut microbiome has been identified as a key effector of metabolic disease gene variants.
Genetics and Epigenetics
Genetics and epigenetics are two critical factors that influence the development of complex diseases. Epigenetic decisions, made at the fork of gene expression, can have a profound impact on an individual’s health. Moreover, complex genotype-phenotype relationships in neurodevelopmental disorders have been observed, highlighting the need for further research in this area. The dark genome, which was previously thought to be inactive, has also been found to play a significant role in the development of various diseases.
The study of genetics and epigenetics has led to a greater understanding of the intricate relationships between genes, environment, and disease. This knowledge has paved the way for the development of new therapies and treatments, such as precision medicine, which takes into account an individual’s unique genetic profile. Furthermore, the use of AI-powered research tools, such as Amazon Bio Discovery, has accelerated the discovery of new genetic variants and their associations with various diseases.
Biotech Research and Innovation
The biotech industry has witnessed significant innovation in recent years, with the development of new technologies and research tools. The launch of Amazon Bio Discovery is a testament to the growing importance of AI-powered research in the life sciences. This platform is expected to accelerate the discovery of new genetic variants and their associations with various diseases, leading to the development of new therapies and treatments.
In addition to AI-powered research, other biotech companies, such as Amgen, are also contributing to the advancement of biotech research. Amgen’s lab has provided students with hands-on experience in biotech equipment, promoting the next generation of biotech researchers. The Toronto Life Sciences and Biotech Summit, where Xtalks has been named a media partner, is another example of the growing interest in biotech research and innovation.
Challenges and Opportunities
Despite the significant advancements in biotech research, there are still several challenges that need to be addressed. One of the major challenges is the translation of scientific discoveries into clinical applications. Europe, in particular, has been struggling to turn world-class science into world-class scale, highlighting the need for greater investment and support for biotech research.
However, there are also opportunities for growth and innovation in the biotech industry. The use of biotech equipment in schools, such as Cumberland High, is promoting the next generation of biotech researchers. Moreover, the work of quiet heroes behind local biotech breakthroughs is finally getting the recognition it deserves, highlighting the importance of collaboration and innovation in the biotech industry.
Future Directions
The future of biotech research looks promising, with significant advancements expected in the coming years. The use of AI-powered research tools, such as Amazon Bio Discovery, is expected to accelerate the discovery of new genetic variants and their associations with various diseases. Moreover, the development of new therapies and treatments, such as precision medicine, is expected to improve patient outcomes and quality of life.
In conclusion, the biotech industry has witnessed significant advancements in recent years, with a major focus on understanding the complexities of various diseases. The study of genetics and epigenetics has led to a greater understanding of the intricate relationships between genes, environment, and disease, paving the way for the development of new therapies and treatments. As the industry continues to evolve, it is expected that we will see significant innovations and breakthroughs, leading to improved patient outcomes and quality of life.